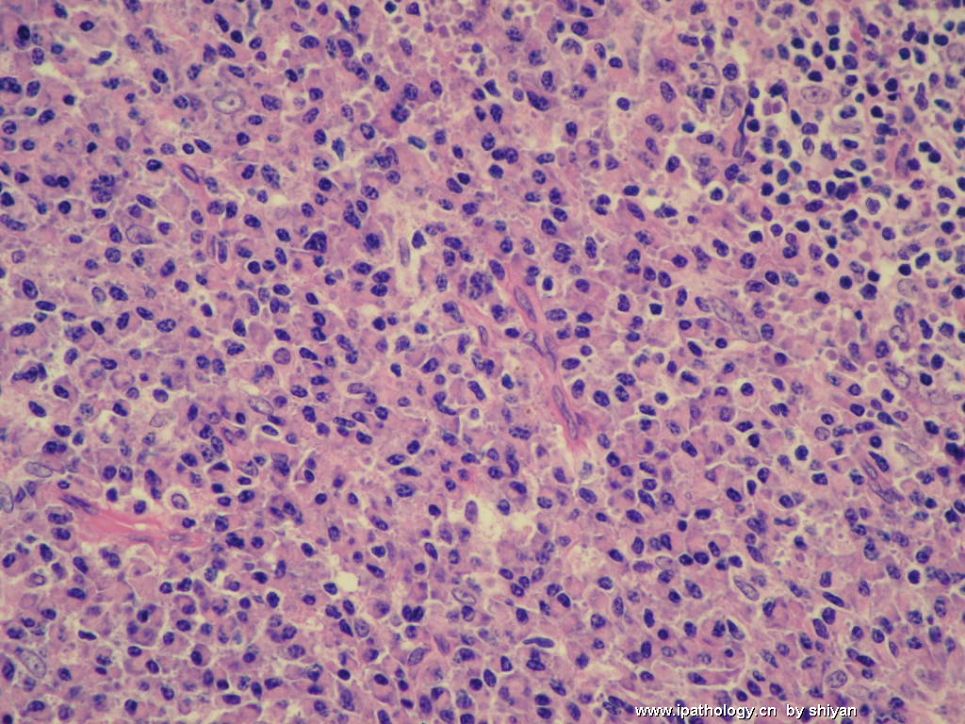

| 图片: | |
|---|---|
| 名称: | |
| 描述: | |
- 会1582
| 姓 名: | ××× | 性别: | 女 | 年龄: | 30 |
| 标本名称: | |||||
| 简要病史: | 便血2月,一周前肛管活检,直径1.5cm。无淋巴结肿大,无发热等不适,肝脾不大。 | ||||
| 肉眼检查: | |||||

名称:图1
描述:图1

名称:图2
描述:图2

名称:图3
描述:图3

名称:图4
描述:图4

名称:图5
描述:图5
名称:图6
描述:图6

名称:图7
描述:图7

名称:图8
描述:图8

名称:图9
描述:图9

名称:图10
描述:图10

名称:图11
描述:图11

名称:图12
描述:图12
标签:
-
本帖最后由 于 2007-12-17 19:03:00 编辑
×参考诊断
基本符合浆细胞瘤。
-
liguoxia71 离线
- 帖子:4174
- 粉蓝豆:3122
- 经验:4677
- 注册时间:2007-04-01
- 加关注 | 发消息































